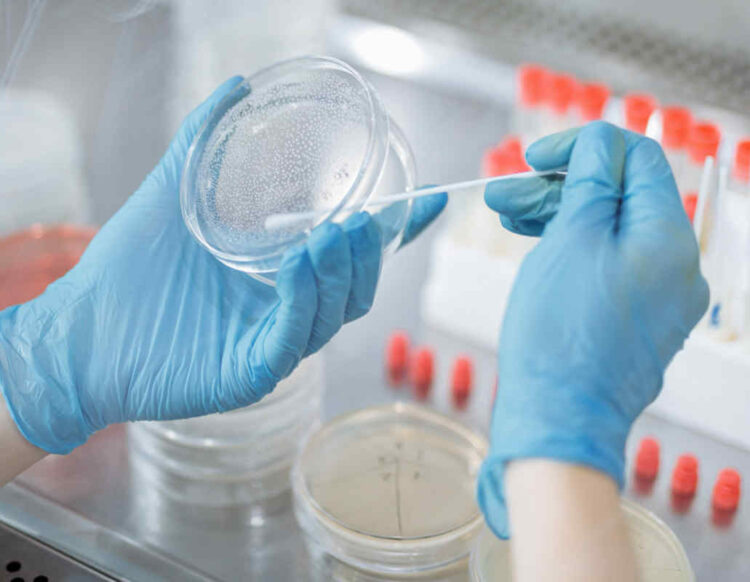
Covid Italia, Sestilli: picco contagi fra 15 giorni

L’ondata di contagi covid in Italia, spinta anche dalla variante Omicron 5, arriverà al picco tra 2 settimane. E’ lo scenario che delinea all’Adnkronos Salute il fisico Giorgio Sestili, che fin dall’inizio della pandemia analizza e monitora l’andamento epidemico di Sars-CoV-2, analizzando i dati del monitoraggio settimanale Iss-ministero della Salute.
“La nuova ondata per quanto riguarda i contagi c’è ed è partita a fine maggio con una forte accelerazione, in cui l’Rt è passato da 0,78 il minino toccato a fine maggio per poi risalite in un mese.
C’è poi anche da evidenziare la forte sottostima dei casi positivi rispetto al passato.
Covid in Italia: il picco?
Probabile tra 15 giorni, come accaduto in Portogallo che ha vissuto la nostra situazione un mese prima, la loro ondata sicuramente spinta dalle variante Omicron Ba.4 e Ba.5, è partita il 25 aprile e ha raggiunto i picco dopo 30-40 giorni e ora è scesa molto velocemente. In questo momento in Portogallo l’incidenza dei casi è la stessa che si aveva quando è partita l’ondata”, spiega Sestili.
“Le varianti Omicron ci stano abituando a vampate veloci di risalita dei casi – aggiunge l’analista – Ormai penso che l’obiettivo sia quello di rendere il virus endemico e quindi lasciarlo circolare.
Manterrei la mascherina al chiuso però: per un livello di protezione che ha un costo minimo di impegno e poi perché è comunque una difesa dal contagio.
Un virus endemico non significa abbassare la guarda – rimarca il fisico – ha una forte capacità di mutare e per ora ci è andata bene ma non sappiamo se la prossima mutazione potrebbe portare una maggiore patogenicità.
Quello che serve per non farci trovare impreparati – conclude – è rafforzare la nostra capacità di monitoraggio e sequenziamento”. (di Adnkronos)